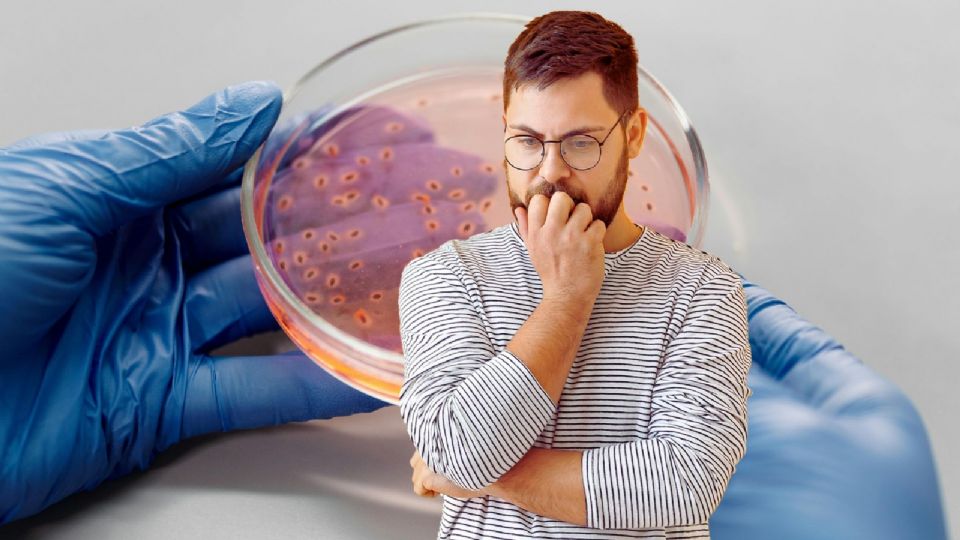
Esta nueva mutación confiere a las bacterias una resistencia completa a toda la familia de los aminoglucósidos.

Un equipo internacional de científicos ha encendido las alarmas tras identificar un gen bacteriano que podría representar una de las amenazas más serias para la salud pública global: el gen npmA2, una variante del gen npmA descubierto por primera vez en Japón en 2003.
Esta nueva mutación confiere a las bacterias una resistencia completa a toda la familia de los aminoglucósidos, antibióticos esenciales en tratamientos contra enfermedades como la tuberculosis o infecciones respiratorias en pacientes hospitalizados.
El hallazgo, liderado por el microbiólogo Bruno González Zorn, de la Universidad Complutense de Madrid, revela que el gen ha sido detectado ya en al menos seis países, incluidos Estados Unidos, Alemania, Reino Unido, China, Francia y Australia, y está principalmente presente en la bacteria Clostridioides difficile, causante de diarreas severas y potencialmente letales en personas inmunocomprometidas.
Te podría interesar
Un gen resistente que podría volver "incurables" muchas infecciones
El gen npmA2 se comporta de forma distinta a otros mecanismos conocidos de resistencia, ya que otorga inmunidad total a una familia entera de antibióticos, algo poco común en el mundo microbiano. Según González Zorn, esta clase de adaptaciones genéticas “pueden hacer que algunas infecciones sean prácticamente incurables”.
El análisis fue realizado con más de dos millones de genomas bacterianos almacenados en la base de datos internacional AllTheBacteria, y sus resultados fueron publicados en la revista Nature Communications. Aunque su presencia todavía es baja (alrededor del 0.34% de las muestras de Clostridioides difficile), su propagación silenciosa preocupa seriamente a la comunidad científica.
Te podría interesar
La expansión también ha sido confirmada en un hospital holandés, donde se identificó en un brote de Enterococcus faecium, un patógeno letal para pacientes hospitalizados. La situación actual abre una ventana crítica de oportunidad para prevenir su diseminación global, advierte González Zorn.
Científicos llaman a la acción inmediata para evitar una crisis sanitaria
Tanto González Zorn como otros expertos, como Rafael Cantón, jefe de Microbiología del Hospital Ramón y Cajal en Madrid, coinciden en que la detección temprana es clave para evitar un escenario donde el npmA2 esté presente en múltiples unidades de cuidados intensivos alrededor del mundo.
“Estamos perdiendo familias enteras de antibióticos”, advierte Cantón, quien recuerda que hace apenas unas décadas la mayoría de las bacterias eran fácilmente controlables. Hoy, el uso excesivo de antibióticos ha generado un entorno ideal para que genes como npmA2 se diseminen rápidamente y sin control.
Los especialistas urgen a los gobiernos, instituciones médicas y centros de investigación a desarrollar sistemas de vigilancia genética, herramientas diagnósticas tempranas y políticas de uso responsable de antibióticos. “Si actuamos ahora, todavía estamos a tiempo”, concluye González Zorn.